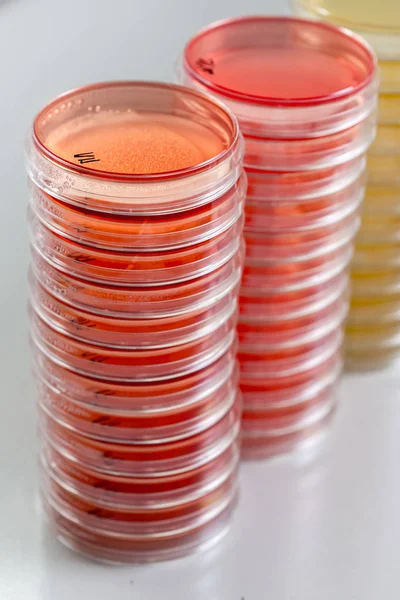
Mikrobiyoloji lab Bakteriyolojinin laboratuvar arka plan üzerinde kırmızı ve sarı petri yemekler küçük yığınlardaki.
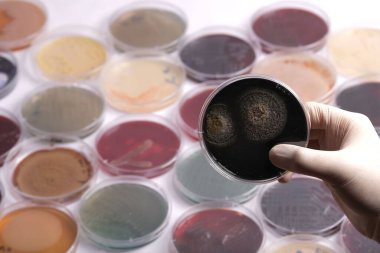
Farklı kültürleri barındıran çeşitli petri kaplarıyla çevrili bir petri kabını tutan bir el.

Mikrobiyoloji lab Bakteriyolojinin laboratuvar arka plan üzerinde kırmızı ve sarı petri yemekler küçük yığınlardaki.
Özel Boyut
(3589 x 5383, jpg)
Geniş Lisanslama
(3589 x 5383, jpg)
En Çok Aranan Kelimeler
KırmızıCam.donanımsatırÇelikİlaç.Sağlık hizmetleriTıbbiyığınİç mekanGelenekselmesleğiprofesyonelsahneodaEğitimbiyolojiDeneyCam eşyalar.LaboratuvarBilimpaslanmazGüvenliSıralamaişyeriaraştırmaGün ışığıanalizBilimselsınıfTabaklartabakBiyoteknoloji.BakterilerMikrobiyolojimikroplartestlermikroskopiPetrikırımimmanuel kantmikroorganizmalarbakteriyolojininsuşlarımikroskoplarBenzer İçerikler